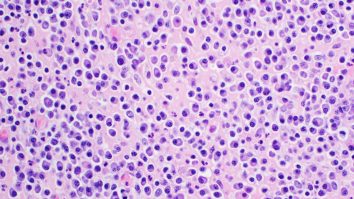
STUDIU. Mielomul multimul, un cancer al sângelui adesea considerat incurabil, ar putea avea leac

- Prima poezie a lui Eminescu a apărut în 1866 cu titlul ”De-asiu avé…” în revista Familia.
- După ”De-aș avea”, Iosif Vulcan a publicat următoarele poezii ale lui Eminescu pe prima pagină din Familia.
- Sistemul ortografic latin al limbii române a devenit oficial în 1881, sub conducerea lui Titu Maiorescu.
Știi din școală că prima poezie a lui Eminescu a fost publicată de Iosif Vulcan, în revista Familia, de la Pesta. Pe atunci, textele aveau o scriere care poate părea amuzantă astăzi.
Dar era o perioadă cu profunde schimbări politice și sociale, care s-au întins chiar mult după ce „De-aș avea” a apărut în 1866.
Debutul Literar al Lui Mihai Eminescu
Exemplarele originale ale publicațiilor de demult ne oferă detalii nebănuite. „De-aș avea”, despre care știm că a fost prima poezie publicată a lui Eminescu, sună cu totul altfel în revista Familia din martie 1866.

Iosif Vulcan, pe care îl vedem în fotografiile de epocă drept un domn sobru, era și el tânăr pe atunci, la doar 25 de ani, și vizibil entuziasmat de debutantul Eminescu.
„Cu bucurie deschidem colonele revistei nostre acestui june numai de 16 ani, care, cu primele sale încercări poetice trimise nouă, ne-a surprins plăcut”.
Însă pe noi în 2025 ne surprinde acest limbaj arhaic, parcă din evul mediu. Era perioada transformării profunde a scrierii în limba română, a trecerii de la alfabetul chirilic la cel latin. A fost un proces lung început în anii 1850, iar limbajul folosit în Familia în 1866 era doar o variantă din multe altele folosite în spațiul românesc.
Alfabetul latin a devenit oficial în 1881, dar dezbaterile ortografice au continuat încă decenii după aceea. Oricum, Vulcan a fost atât de fascinat de junele Eminescu încât, în același an, 1866, i-a publicat alte două poezii, „Speranța” și „Misteriile Nopții”, chiar pe prima pagină a revistei sale.